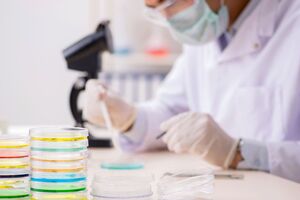
Среди контактировавших с заболевшими новых случаев COVID-19 не обнаружено
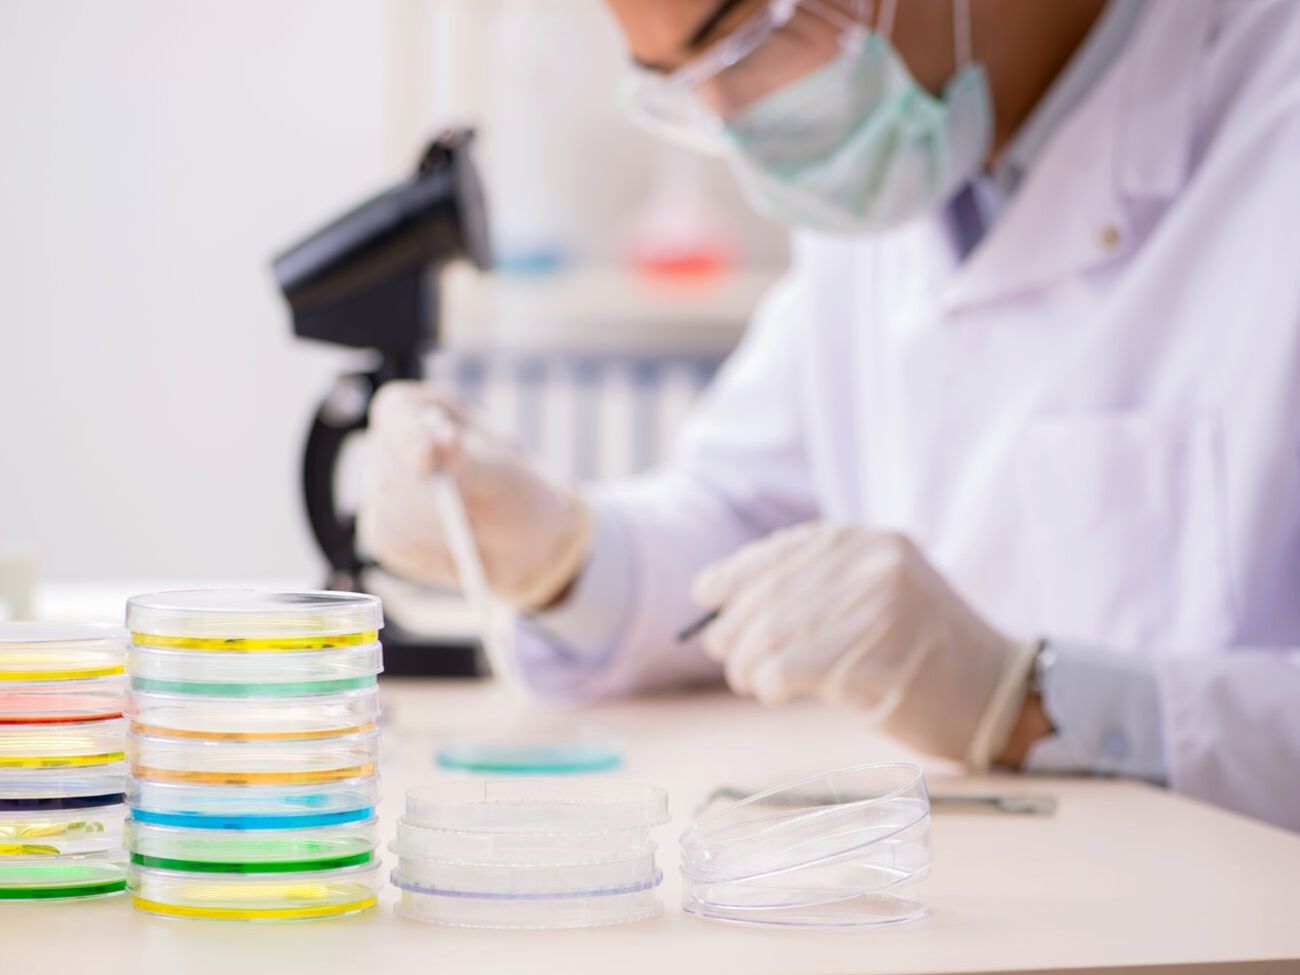
Среди контактировавших с заболевшими новых случаев COVID-19 не обнаружено

Василий Володин


В Киевской области закроют школы, если в них будет меньше 80% привитых от COVID-19 работников – ОГА
16 сентября, 21.57
Общество
Украинская призерка Олимпиады Коляденко решила отдать подаренную ей властями квартиру своему тренеру
25 августа, 18.51
Спорт
В Киевской области построят тренировочную базу для сборных Украины по футболу – ОГА
4 августа, 13.33
Деньги
Кличко занял первое место в рейтинге глав госадминистраций по версии журнала "Корреспондент"
12 июля, 17.26
Политика
24 мая, 15.01
Политика
В Украине начали делать прививки от коронавируса препаратом Pfizer/BioNTech
18 апреля, 15.41
Общество
30 декабря, 15.00
События
В Киевской области из-за коронавируса более 1500 школьников перевели на дистанционное обучение
7 сентября, 17.35
ОбществоПредыдущая
Следующая